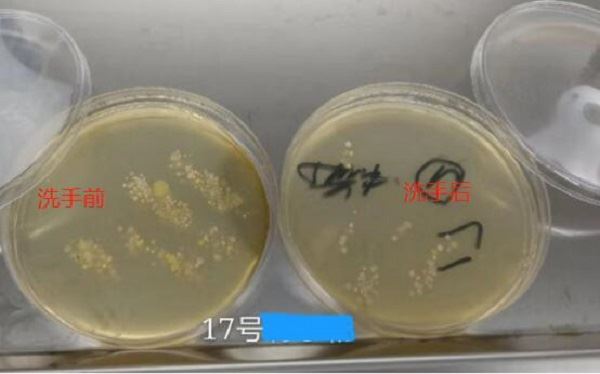

生活是美好的,医学是神奇的,需要让孩子们发现、体验、创造。在2020金鼠年开端之际,孩子们通过学习医疗急救知识、实践医疗器械操作、帮助医生看病等实践内容,齐聚长沙圣达综合门诊部一探医学的神奇之处。
【揭秘超声神奇之旅】
孩子们一大早来到圣达,在讲解完超声和眼科的理论知识后,在医生的带领下进行了自主的行医活动。小小医生行医中,诸多的好奇和疑问,都被带教老师详细解答,小小医生们还通过自己学到的理论知识找到了相应的脏器,成就感满满!

【眼科视力大测试】
意犹未尽之时,带孩子们来到了眼科实践,通过相互给对方测试视力,了解测试视力的原理和为什么定期需要进行视力测试,了解眼睛对于人体的重要性,学习如何在生活中保护好视力,保护好眼睛。

【洗手前后看细菌】
在前面两场实践完成后,大家一同来到检验实验室外围进行参观,领略了高端的血液检查仪器后,在外围进行了洗手前后的取样,实验室对取样的标本进行了培养,给出了培养前后的结果。结果告诫我们,手上有大量细菌,我们在进食前需要认真洗手,以避免病从口入!

【急救知识大互动】
刘科副教授现场为孩子们讲解了心肺复苏的急救知识,孩子们积极踊跃的回答了问题。不得不为孩子们的知识面赞叹!后续由圣达的主管护师唐丝现场教学急救心肺复苏,并利用人体模型为大家讲解了人体构造等医学知识,随后为大家示范了心肺复苏术。
老师讲的认真,孩子听的仔细,在实际操作阶段,同学们更是摩拳擦掌,跃跃欲试,判断,吹气,按压.....同学们虽然做的不是很标准,虽然还很生涩,但是同学们那股认真劲儿值得我们赞扬。
急救知识的学习是非常必要的,当身边的亲人朋友万一有什么突发疾病,掌握急救知识能第一时间缓解患者的病症,急救生命。近年来,发生猝死的几率越来越高,掌握一点急救知识也是对家人朋友的一种责任。

【天瑞简介】
长沙天瑞健康管理有限公司位于长沙市经开区人民东路169号铭诚绿谷11栋,旗下有长沙圣达综合门诊部有限责任公司,长沙卫实医学检验所,长沙康域检测有限公司。
公司主要从事高端体检、第三方检验、基因诊断、病理诊断、影像诊断、远程会诊、健康管理、中医专科、食品药品化妆品检测等业务。(记者 黄靖淞)
【圣达体检项目】
